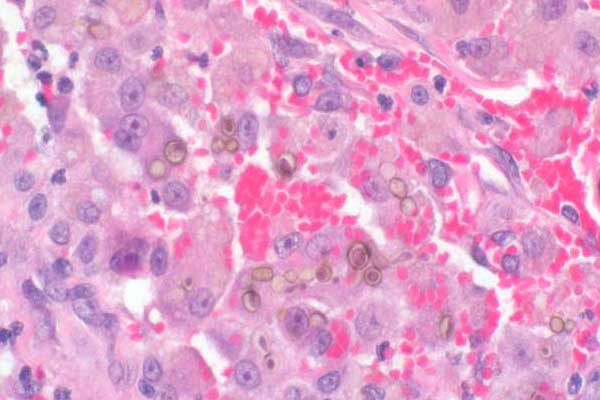
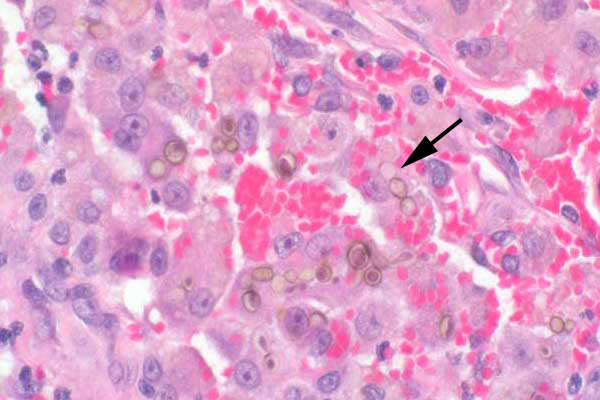

| 40x | Hematoxylin and Eosin | ||||
| Close Window | Macro View | Show Help | Back | |
|
Solitary or chains (pseudohyphae) of pigmented fungi are present within macrophages (arrow).
|
||||
|
||||
| Return | ||||
|
Solitary or chains (pseudohyphae) of pigmented fungi are present within macrophages (arrow).
|
||||